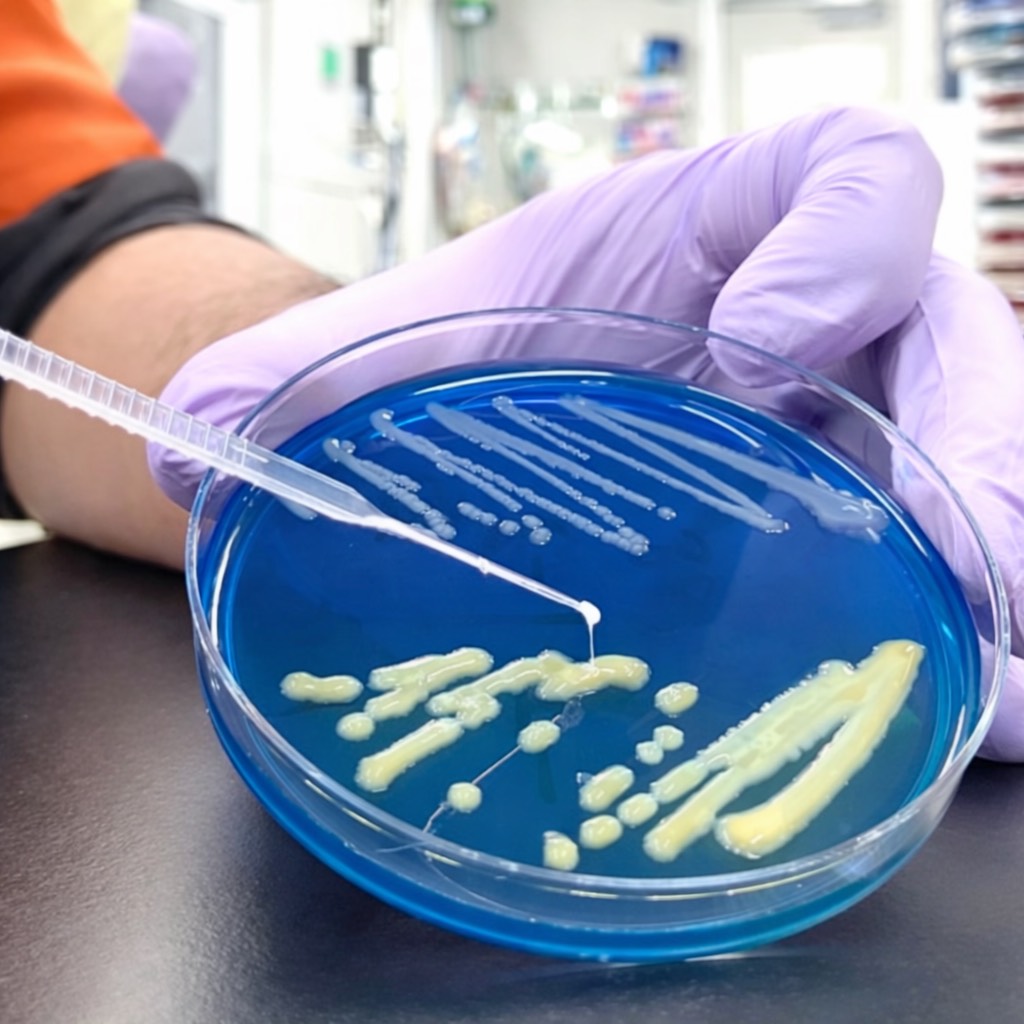

科長のご紹介
| 科長 |
萩谷 英大 Hideharu Hagiya |
| 専門医 |
総合内科専門医
日本感染症学会専門医・指導医
International Society of Travel Medicine Certificate in Travel Health™
Certification Board of Infection Control and Epidemiology, Inc. CIC®
日本結核・非結核性抗酸菌症学会 認定医
日本渡航医学会 認定医療職
日本エイズ学会認定医
日本臨床微生物学会認定医
|
| 専門分野 |
臨床感染症,感染制御 |

私たち感染症内科は,細菌・真菌・ウイルス・寄生虫など,多種多様な微生物による病態の診断と治療を専門としています。当科の目標は「すべての臓器のあらゆる感染症」を対象に,最先端の診断・治療,そして予防医療を提供することです。高度な専門知識を活かし,患者さん一人ひとりに最適な医療を届けるため,日々一丸となって診療に邁進しています。
主な対象疾患
感染症内科では,院内感染症, HIV/AIDS, 薬剤耐性菌, 輸入感染症, 日和見感染症, 渡航ワクチン, 重症感染症, 新興/再興感染症の診療をいたします。
診療内容と特色
- 外来・病棟・集中治療室などで「すべての臓器のあらゆる感染症」を診療いたします。
- 岡山県内唯一の第一種感染症指定医療機関として新興/再興感染症発生時には率先して対応する体制を整えています。
- 岡山県のエイズ治療拠点病院の一つとして機能し,外来・病棟におけるHIV診療に加え,HIV感染症の曝露前予防「PrEP」(Pre-Exposure Prophylaxis通称:プレップ)を希望する方への対応もしています。
- 渡航ワクチン外来を開設し,海外への留学・赴任・派遣に伴って必要なワクチン接種や帰国後の体調不良時の診療を行っています。国内では対応可能な医療機関がまだ少ない黄熱ワクチンにも対応してます。
研究について
感染症学分野ホームページをご覧ください。
診療実績
[各年1月~12月の実績]
| 各種実績 |
2023年 |
2024年 |
2025年 |
| 初診患者数(人) |
30 |
25 |
15 |
| 再診患者数(人) |
507 |
568 |
660 |
| 1日平均外来患者数(人) |
2.2 |
2.4 |
2.8 |
| 新入院患者数(人)(※1)
|
0 |
0 |
0 |
| 1日平均入院患者数(人) |
0.0 |
0.0 |
0.0 |
| 平均在院日数(日) |
0.0 |
0.0 |
0.0 |
(※1)入院実施をした診療科で計上(転科先は含めない)
コンサルテーション実績
スタッフ紹介


 私たち感染症内科は,細菌・真菌・ウイルス・寄生虫など,多種多様な微生物による病態の診断と治療を専門としています。当科の目標は「すべての臓器のあらゆる感染症」を対象に,最先端の診断・治療,そして予防医療を提供することです。高度な専門知識を活かし,患者さん一人ひとりに最適な医療を届けるため,日々一丸となって診療に邁進しています。
私たち感染症内科は,細菌・真菌・ウイルス・寄生虫など,多種多様な微生物による病態の診断と治療を専門としています。当科の目標は「すべての臓器のあらゆる感染症」を対象に,最先端の診断・治療,そして予防医療を提供することです。高度な専門知識を活かし,患者さん一人ひとりに最適な医療を届けるため,日々一丸となって診療に邁進しています。